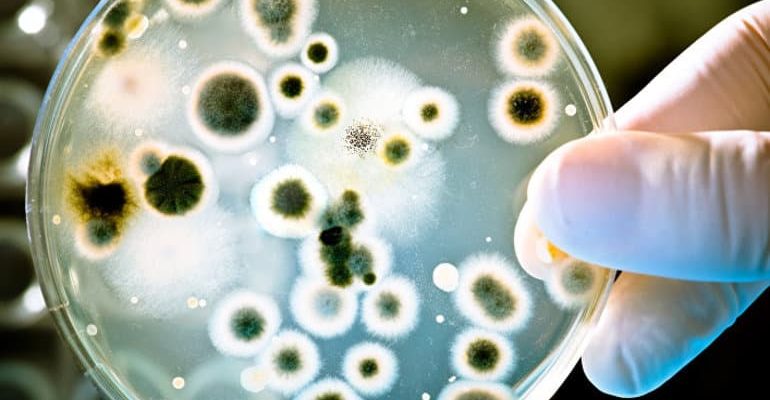

Окружающий мир
Роль бактерий в природе очень важна, они являются главными участниками всех биологических круговоротов веществ. Основная часть неорганических и органических
При рассказе о дубе, описание для детей должно содержать основные характеристики могучего дерева. Его почитают в средней полосе России, он является олицетворением
В народе это растение называют трилистником. Оно является представителем семейства бобовых, растет в дикой природе на лугах и полях. На школьных уроках
Сообщение о морже повествует о крупнейших ластоногих, относящихся к классу млекопитающих. Животное называют уникальным жителем холодных вод Арктики.
Это растение относится к классу Однодольные семейства Орхидные. Редкий вид постепенно исчезает в дикой природе, поэтому в России венерин башмачок занесен Красную книгу.
Сообщение о хомяке поможет подготовиться к уроку окружающего мира ученику 2 — 4 классов. Хомяки – мышеобразные животные, их изучают в теме «Грызуны».
Сообщение о дельфине задают школьникам 3 — 4 класса подготовить к уроку окружающего мира. В нем нужно представить краткое описание млекопитающего и рассказать
Морской конек относится к роду небольших морских лучепёрых рыб семейства игловых отряда иглообразных. Эту экзотическую рыбу ученые считают самой
Парусные корабли строились еще с глубокой древности. Как считают ученые, первенство принадлежит египетской цивилизации, появившейся больше 7 тыс.
В СССР перед полетом человека в открытое пространство проводили исследования по влиянию различных неземных нагрузок на живой организм. Для этого использовали животных.